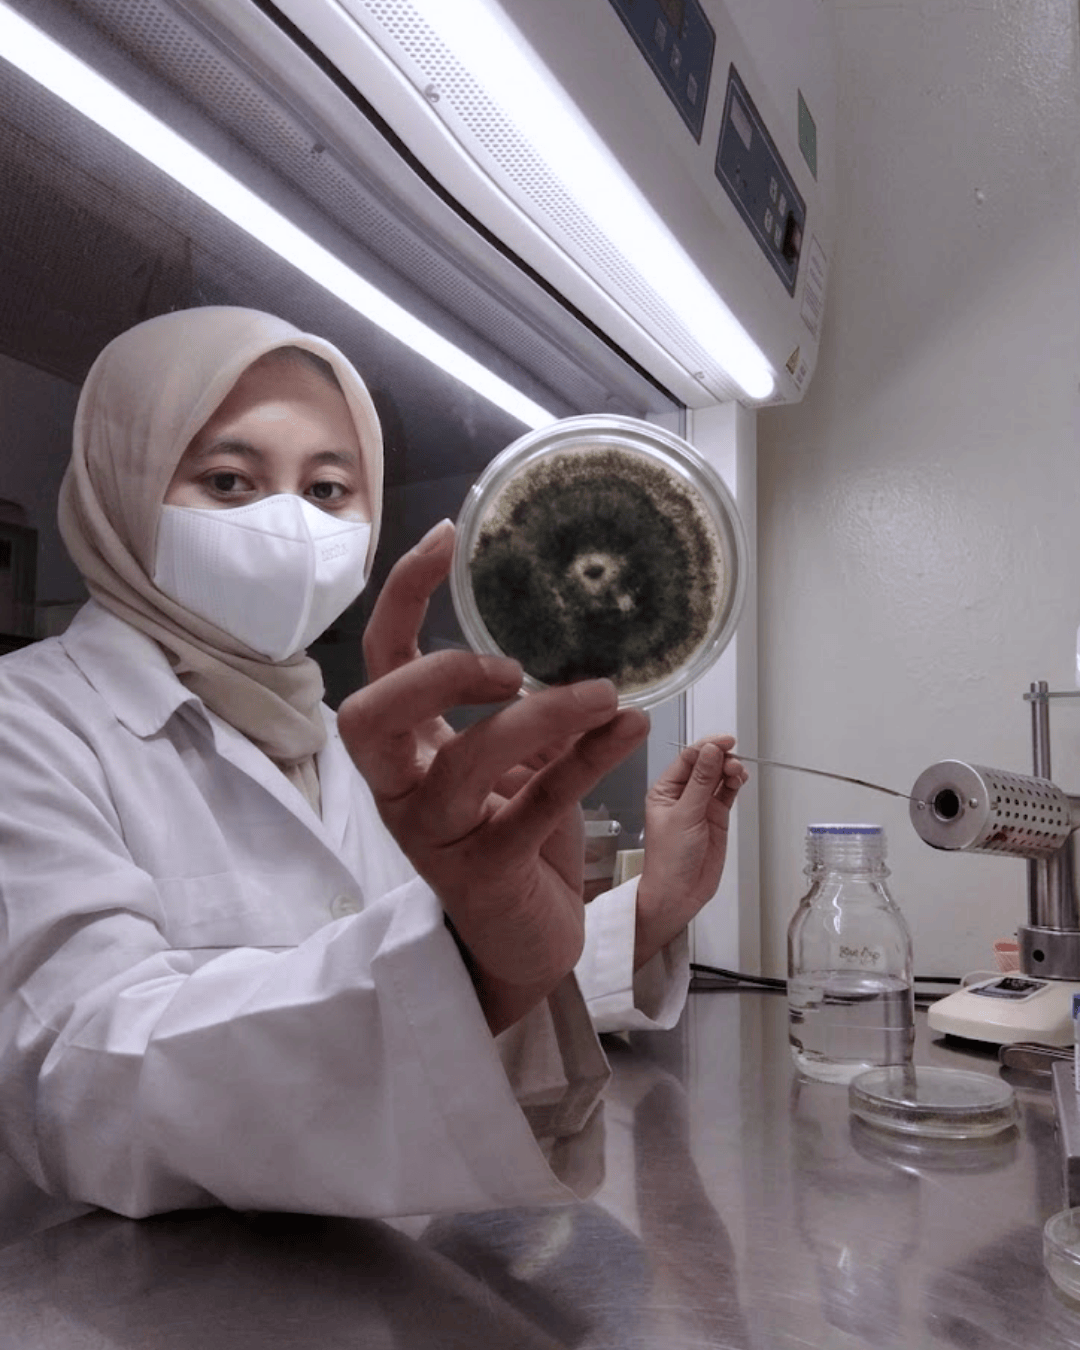
tanahara pengamatan analisis kesehatan tanaman

Tanah yang sehat
Adalah Pondasi Kehidupan
Kami percaya bahwa perubahan nyata kesehatan tanah Indonesia tidak bisa terjadi tanpa bantuan dari banyak tangan. Tanahara hadir untuk menjadi jembatan dari harapan besar itu, kami melangkah bersama petani, relawan, pendidik, dan siapapun yang peduli dengan kondisi kesehatan tanahnya.
Tentang Kami
Satu Pintu Solusi Perbaikan Lahan
TANAHARA adalah portal pengetahuan kesehatan tanah yang akan menemanimu dalam perjalanan pemulihan lahan. Tanahara menyediakan layanan diagnosis tanah berbasis data, produksi input alami, , pendampingan lapang, dan juga program restorasi lahan pertanian, perkebunan, dan kawasan hutan yang memerlukan pemulihan ekosistem tanah secara terukur dan sistematis.

SEKOLAHARA
Knowledge Sharing
Ruang Belajar tentang Kesehatan Tanah untuk petani, agronomist, dan praktisi lapang.
Online Course, Workshop, pelatihan trainer, dan konten edukasi berbasis riset.

PETAHARA
Monitoring & Analysis
Layanan survei tanah, uji laboratorium, dan monitoring progres berkala.
Dashboard kondisi kesehatan lahan real-time, sebagai dasar diagnosis, rekomendasi, dan pelaporan yang ter-verifikasi.

OLAHARA
Natural-Input Solution
Input alami terverifikasi, menyediakan biokompos, biochar, pupuk hayati, dan mineral amendemen tanah.
Mitra Layanan Produksi, Penyusunan SOP, dan Pelatihan tenaga produksi.
Yang Kami Lakukan untuk Lahan Indonesia yang Lebih Baik
Belajar, Berbagi, Berstrategi, dan Beraksi

Penelitian dan Pengembangan
Uji efikasi input alami dan studi komparasi lapang untuk menghasilkan rekomendasi berbasis data.

Survey & Pemetaan Lapangan
Pengambilan sampel tanah multi-titik langsung di lapang, menjadi dasar diagnosis dan program perbaikan Tanahara.

Produksi Input Alami & Agen Hayati
Produksi biokompos, pupuk hayati, dan agen biologis yang sudah teruji untuk digunakan di lahan.

Sekolah Lapangan Petani
Pelatihan langsung di lahan, belajar membaca kondisi tanah, memilih input yang tepat, dan diterapkan di kebun.

Tour Laboratorium Petani
Petani melihat langsung proses analisis tanah di lab, memahami mekanisme apa yang terjadi di bawah permukaan tanah.

Restorasi Lahan Rusak dan Kritis
Perbaikan lahan terdegradasi berat dimulai dari persiapan lahan hingga penanaman awal berbasis input alami.
Analisis Kesehatan Tanah & Tanaman
Uji lab untuk mengidentifikasi kondisi biologi, kimia, dan fisika tanah, dasar dari rekomendasi yang Tanahara berikan.

Develop Modul Ajar dan SOP Produksi
Penyusunan modul pelatihan dan SOP produksi input alami terstandar, pengetahuan disampaikan secara konsisten.
SEKOLAHARA - Knowledge Transfer
Lorem ipsum dolor sit amet, consectetur adipiscing elit. Ut elit tellus, luctus nec ullamcorper mattis, pulvinar dapibus leo.
PETAHARA - Survey, Monitoring, & Analysis
Lorem ipsum dolor sit amet, consectetur adipiscing elit. Ut elit tellus, luctus nec ullamcorper mattis, pulvinar dapibus leo.
OLAHARA - Natural Input Based Solutions
Lorem ipsum dolor sit amet, consectetur adipiscing elit. Ut elit tellus, luctus nec ullamcorper mattis, pulvinar dapibus leo.
A Light Wind Swept Over The Corn, And All Nature Laughed In The Sunshine.
Tanah yang pulih dimulai dari kita.
Lorem ipsum dolor sit amet, consectetur adipiscing elit. Ut elit tellus, luctus nec ullamcorper mattis, pulvinar dapibus leo.